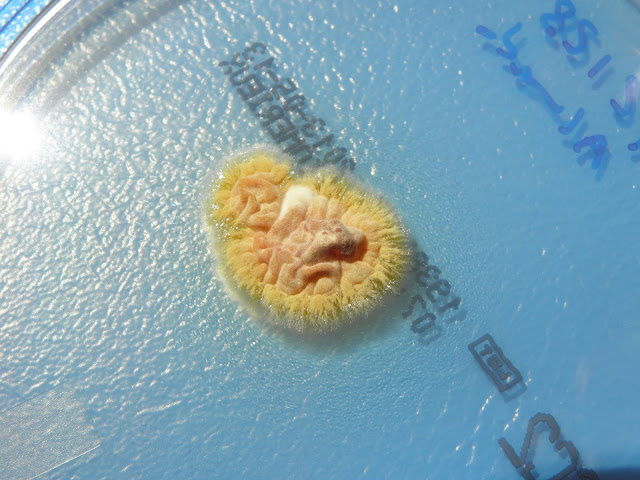

O Trichophyton soudanense é um fungo filamentoso septado hialino, fisiopatologicamente é classificado como dermatófito. É um agente infeccioso que afecta exclusivamente o ser humano.
O Trichophyton soudanense é causa frequente de tinha capitis em África, provoca uma tinha tonsurante tricofitica endotrix (várias placas muito pequenas por vezes coalescentes com restos de cabelos muito curtos quase inexistentes). O T. soudanense é, também, responsável por lesões circinadas e por onicomicoses
Em Portugal é frequente o seu isolamento em imigrantes africanos. Um estudo epidemiológico feito no início do século XXI, no Senegal, evidenciou que o T. soudanense é o dermatófito mais prevalente na tinea capitis.
O caso clínico aqui documentado ocorreu no nosso hospital.
A colónia é de crescimento lento, 2 cm em 30 dias, e apresenta algum polimorfismo apresentando sulcos e pregas, à periferia existe uma franja de crescimento submerso no meio de cultura. A cor varia de amarelo pálido a laranja/pêssego.
Ao exame microscópico as hifas apresentam ramificações com orientação progressiva e regressiva (hifas reflexas) formando um ângulo agudo com a hifa mãe. Artrosporos e clamidosporos são frequentes em culturas velhas, os microconideos, piriformes a ovoides, são raros e os macroconideos estão ausentes.
De acordo com estudos moleculares alguns autores consideram o T. soudanense relacionado com o Trichophyton violaceum enquanto que outros, através da mesma metodologia, os consideram intimamente relacionados com o Trichophyton rubrum
 |
A colónia apresenta um crescimento lento.
A colónia apresenta sulcos e pregas e à periferia existe uma franja de crescimento submerso no meio de cultura.
A cor varia de amarelo pálido a laranja/pessego. |
 |
| Várias colónias: sementeira de suspensão aquosa. |
 |
| A cor do reverso é laranja/pessego. |
 |
| Franja periférica de crescimento submerso no meio |
Outra estirpe:
 |
| As hifas apresentam ramificações com orientação progressiva e regressiva (hifas reflexas) formando um angulo agudo com a hifa mãe. |
 |
| Hifas reflexas. |
 |
| Hifas reflexas |
 |
| Os microconideos, piriformes a ovoides, são raros e os macroconideos estão ausentes. |
 |
| Pigmento característico. |
OUTRA ESTIRPE
 |
| Reverso da colónia. |
 |
| Reverso da colónia. |
 |
| À transparência. |
 |
| Reverso da colónia |